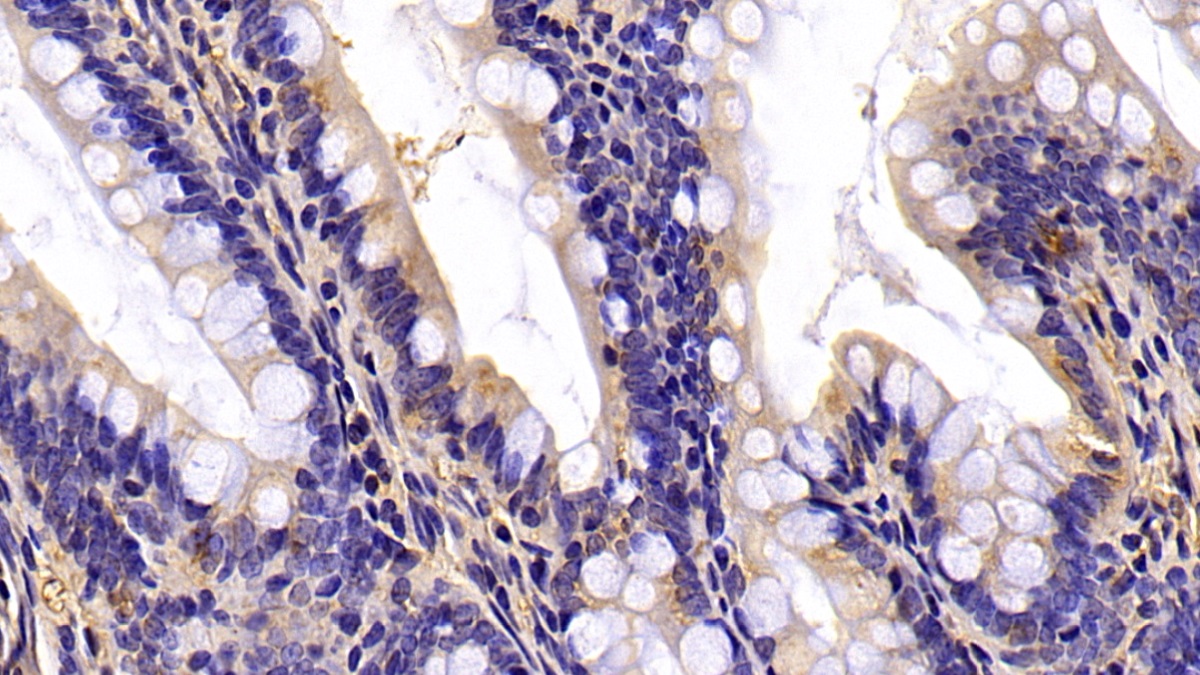

Monoclonal Antibody to Beta Actin (ACTB) 

Actin Beta; ACT-B; PS1TP5BP1; Actin, cytoplasmic 1; Actin, cytoplasmic 1, N-terminally processed
- UOM
- FOB US$ 130.00 US$ 302.00 US$ 432.00 US$ 1,080.00 US$ 4,320.00
- Quantity
Overview
Properties
- Product No.MAB340Mi23
- Organism SpeciesCanis familiaris; Canine (Dog), Sus scrofa; Porcine (Pig), Bos taurus; Bovine (Cattle) Same name, Different species.
- ApplicationsWB; IHC; ICC/IF
If the antibody is used in flow cytometry, please check FCM antibodies.
Research use only - DownloadInstruction Manual
- CategorySignal transductionDevelopmental scienceBone metabolism
- SourceMonoclonal antibody preparation, Host Mouse
- Ig Isotype IgG2a Kappa, Clone Number C6
- PurificationProtein A + Protein G affinity chromatography
- LabelNone
- Immunogen RPB340Mi01-Recombinant Beta Actin (ACTB)
- Buffer Formulation0.01M PBS, pH7.4, containing 0.05% Proclin-300, 50% glycerol.
- TraitsLiquid, Concentration 1mg/mL
Sign into your account
Share a new citation as an author
Upload your experimental result
Review

Contact us
Please fill in the blank.
Specifity
The antibody is a mouse monoclonal antibody raised against ACTB. It has been selected for its ability to recognize ACTB in immunohistochemical staining and western blotting.
Usage
Western blotting: 0.01-2µg/mL;
Immunohistochemistry: 5-30µg/mL;
Immunocytochemistry: 5-30µg/mL;
Optimal working dilutions must be determined by end user.
Storage
Store at 4°C for frequent use. Stored at -20°C in a manual defrost freezer for two year without detectable loss of activity. Avoid repeated freeze-thaw cycles.
Stability
The thermal stability is described by the loss rate. The loss rate was determined by accelerated thermal degradation test, that is, incubate the protein at 37°C for 48h, and no obvious degradation and precipitation were observed. The loss rate is less than 5% within the expiration date under appropriate storage condition.
Organism Species More: Homo sapiens (Human), Rattus norvegicus (Rat), Oryctolagus cuniculus (Rabbit), Canis familiaris; Canine (Dog), Sus scrofa; Porcine (Pig), Bos taurus; Bovine (Cattle)Giveaways
Increment services
-
 Antibody Labeling Customized Service
Antibody Labeling Customized Service
-
 Protein A/G Purification Column
Protein A/G Purification Column
-
 Staining Solution for Cells and Tissue
Staining Solution for Cells and Tissue
-
 Positive Control for Antibody
Positive Control for Antibody
-
 Tissue/Sections Customized Service
Tissue/Sections Customized Service
-
 Phosphorylated Antibody Customized Service
Phosphorylated Antibody Customized Service
-
 Western Blot (WB) Experiment Service
Western Blot (WB) Experiment Service
-
 Immunohistochemistry (IHC) Experiment Service
Immunohistochemistry (IHC) Experiment Service
-
 Immunocytochemistry (ICC) Experiment Service
Immunocytochemistry (ICC) Experiment Service
-
 Flow Cytometry (FCM) Experiment Service
Flow Cytometry (FCM) Experiment Service
-
 Immunoprecipitation (IP) Experiment Service
Immunoprecipitation (IP) Experiment Service
-
 Immunofluorescence (IF) Experiment Service
Immunofluorescence (IF) Experiment Service
-
 Buffer
Buffer
-
 DAB Chromogen Kit
DAB Chromogen Kit
-
 SABC Kit
SABC Kit
-
 Long-arm Biotin Labeling Kit
Long-arm Biotin Labeling Kit
-
 Real Time PCR Experimental Service
Real Time PCR Experimental Service
Citations
- Nano-Nutrition of Chicken Embryos. The Effect of in Ovo Administration of Diamond Nanoparticles and L-Glutamine on Molecular Responses in Chicken Embryo Pectoral MusclesNCBI:PMC3856104
- Expression of chloride channels in mouse skin incisional wounds96
- Targeted Elimination of Senescent Beta Cells Prevents Type 1 Diabetes
- Neuroinflammation, Oxidative Stress, and Neurogenesis in a Mouse Model of Chronic Fatigue Syndrome, and the Treatment with Kampo MedicinePubmed: 31902915
- Linc-OIP5 in the breast cancer cells regulates angiogenesis of human umbilical vein endothelial cells through YAP1/Notch/NRP1 signaling circuit at a tumor …Pubmed: 32046779
- Effect of ischemic postconditioning on cell apoptosis and expression of relevant genes in non-culprit coronary arteriesPubmed: 32784207
- Malted Barley Improved the Structure and Function of Gastrocnemius Muscle of Hypercholesterolemic Mother Rats and their Offspring
- Tryptophan Depletion Modulates Tryptophanyl-tRNA Synthetase-Mediated High-Affinity Tryptophan Uptake into Human Cells33261077
- POLRMT mutations impair mitochondrial transcription causing neurological disease33602924
- Indole-linked 1, 2, 3-triazole derivatives efficiently modulate COX-2 protein levels in human THP-1 monocytes by suppressing AGE-ROS-NF-kβ nexusPubmed:34990649
- Isolation and characterization of anti-inflammatory and anti-proliferative compound, for B-cell Non-Hodgkin lymphoma, from Nyctanthes arbor-tristis Linn.Pubmed:35398498
- Investigation of single beam ultrasound sensitivity as a monitoring tool for local hyperthermia treatment in breast cancer